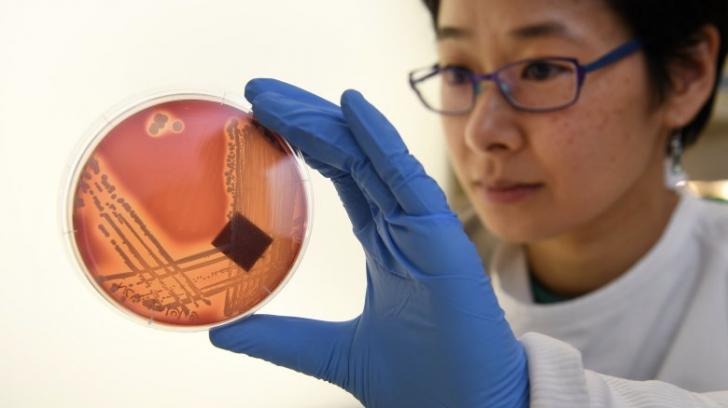
消毒湿巾不小心擦了外阴有事吗,消毒产品你用对了吗

众所周知,消毒湿巾是保持我们家庭健康的有效方法,尤其是在细菌丰富的日子。但是如果不按指示使用它们,它们将不会起作用,甚至可能弊大于利。那么,如何正确使用它们并获得最佳结果呢?这是您应该知道的16件事。
1.消毒和清洁是两件完全不同的事情
您可能没有意识到,但是消毒和清洁是两个截然不同的事情。清洁可以清除表面的细菌和病毒,而消毒则可以使用抗菌成分将其杀死。常规擦拭不需要消毒抹布,但在表面接触生肉,血液或体液以及家人感染流感等传染性疾病时,请使用消毒抹布。
2.消毒湿巾并不意味着您的皮肤

这似乎很明显,但在这里仍然值得一提:不要将消毒湿巾用作抗菌湿巾或尿布湿巾。这些湿巾中的化学物质旨在清洁硬和软表面,而不是人类皮肤。此外,它们会引起皮肤过敏反应,例如瘙痒或脱皮。
3.您需要考虑“联系时间”

为了有效,消毒湿巾需要在表面停留一段时间,具体时间因产品而异。例如,Clorox消毒湿巾的标签指出,您应该将处理过的表面保持明显湿润4分钟,以便对其进行彻底消毒。现在,您知道首先阅读说明是值得的。
4.消毒,冲洗并重复

定期使用消毒湿巾对孩子的玩具进行消毒是明智的,尤其是在流行期间。但是请记住,在将玩具退还给孩子之前,请用清水洗净玩具,因为这些小孩往往会将所有东西放入口中,并可能吞下残留的化学物质。该规则也适用于任何与食物接触的表面,例如切菜板或餐具。
5.避免用消毒湿巾擦拭眼镜

如果擦镜布用完了,请勿尝试使用消毒擦镜布代替。正如我们前面提到的,消毒湿巾中的化学物质会刺激我们的皮肤。如果它们直接与您的眼睛接触,您可能最终会去看医生。
6.不要在吸收性表面上使用消毒湿巾
切勿在地毯等吸收性表面上使用消毒湿巾,因为这不仅会损坏物体,还会降低消毒能力。也要避免未完成,未密封,未上漆,上蜡或上油的表面。Clorox湿巾也不应在铜,铝或其他抛光表面上使用。消毒表面之前最好检查标签。如有疑问,请先测试一小块区域。
7.不要用消毒抹布擦花岗岩台面

在厨房使用消毒湿巾进行消毒,捡起面包屑并清除坚硬的烹饪污渍并不少见。但是您真的应该三思而后行在花岗岩台面上使用它们。为什么?花岗岩是一种多孔材料,通常将其密封以进行保护。消毒湿巾实际上会吞噬密封胶,使漂亮的花岗岩表面处于危险之中。
8.用消毒湿巾清洁皮革不是一个好主意
使用消毒湿巾来清洁和消毒真皮沙发或汽车的皮革座椅非常容易,但是请停止这样做,因为湿巾中的酒精会导致皮革失去天然油脂并变干。
9.不,您不能在车内存放消毒湿巾
有必要准备一些日常使用的消毒湿巾,但应将其保持在室温下。如果在汽车等极端高温或极冷的地方,您很可能会破坏防腐剂并“折叠霉菌”。顾名思义,这是一种隐藏在湿巾褶皱中的真菌。想象一下,将其散布在方向盘上。ek!
10.消毒湿巾不会永远保持良好状态

即使将它们存放在正确的位置,也不应指望消毒湿巾永远保持新鲜。该产品通常会在2年后开始失去部分功效。Lysol消毒湿巾的代表透露,它们的湿巾没有有效期,但“自生产之日起保质期为两年”。好吧,您不必记住确切的日期,因为气味会告诉所有人。如果气味变弱了,建议您更换它们。
11.您可能正在用消毒湿巾传播细菌

尽管消毒湿巾可以在多种表面上使用,但这并不意味着您可以在多个表面上使用单个湿巾,因为最终可能会传播出比要杀死的细菌还要多的细菌。因此,这里的规则是“新地方,新抹布”。
12.消毒湿巾会导致超级细菌
尽管消毒湿巾是对抗细菌的可靠*器武**,但过度使用它们会导致被称为“超级细菌”的耐抗生素细菌的生长。研究发现,某些超级细菌如MRSA能够通过消毒湿巾传播。因此,当您必须使用消毒湿巾时,请确保遵循说明。
13.大流行期间如何使用消毒湿巾

为了保持我们家人的健康,疾病控制与预防中心建议每天对触摸过的表面进行消毒,包括“桌子,门把手,电灯开关,工作台面,把手,书桌,电话,键盘,马桶,水龙头和水槽”。但是要记住的一件事是,在使用消毒剂时请遵循说明。否则,您的工作可能会浪费。
14.消毒湿巾不能代替肥皂和水

正如世界卫生组织所强调的那样,用肥皂和水清洗是减少细菌数量和降低感染风险的最佳方法。急诊室医师桑普森·戴维斯(Sampson Davis)博士对此表示完全不同意,他说:“抵御细菌的第一道防线始终是肥皂和水。即使是受污染的表面也应该消毒,这也是事实。”
15.如果您的消毒湿巾变干了怎么办?
如果消毒湿巾变干了,而商店中没有新的消毒湿巾,则可以通过以下方式恢复它们:将70%异丙醇(擦拭)倒入罐中,紧紧密封容器,并允许湿巾吸收酒精完全在使用之前。
16.切勿将消毒湿巾扔进马桶
大多数消毒湿巾具有非织造基材,必须将其放在垃圾桶中。请勿将它们冲洗到马桶上,因为这会导致管道和化粪池堵塞。